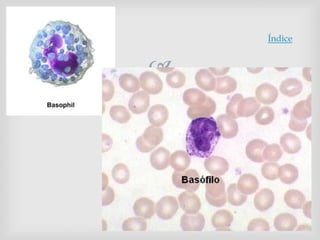

Índice

Este documento describe las células migrantes del tejido conectivo. Se originan en la médula ósea y viajan por la sangre para llegar al tejido conectivo, donde ejercen funciones como la fagocitosis, la presentación de antígenos y la respuesta inmune. Las principales células migrantes son los macrófagos, plasmocitos, leucocitos (linfocitos, granulocitos neutrófilos, basófilos, eosinófilos y monocitos), y células dendríticas.